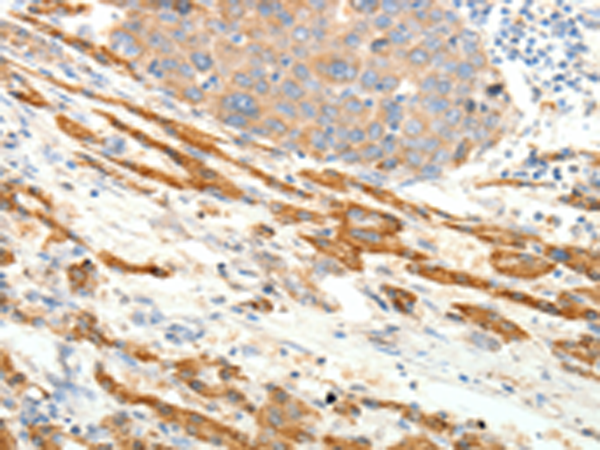
一抗

中文名稱: 兔抗PTHLH多克隆抗體
英文名稱: Anti-PTHLH rabbit polyclonal antibody
別 名: HHM, PLP, BDE2, PTHR, PTHRP
抗 原: PTHLH
儲 存: 冷凍(-20℃)
宿 主: Rabbit
相關(guān)類別: 一抗
反應(yīng)種屬: Human, Mouse, Rat
標(biāo) 記物: Unconjugate
克隆類型: rabbit polyclonal
技術(shù)規(guī)格
|
Background: |
The protein encoded by this gene is a member of the parathyroid hormone family. This hormone regulates endochondral bone development and epithelial-mesenchymal interactions during the formation of the mammary glands and teeth. This hormone is involved in lactation possibly by regulating the mobilization and transfer of calcium to the milk. The receptor of this hormone, PTHR1, is responsible for most cases of humoral hypercalcemia of malignancy. Four alternatively spliced transcript variants encoding two distinct isoforms have been observed. There is also evidence for alternative translation initiation from non-AUG (CUG and GUG) start sites, in-frame and downstream of the initiator AUG codon, to give rise to nuclear forms of this hormone. |
|
Applications: |
ELISA, IHC |
|
Name of antibody: |
PTHLH |
|
Immunogen: |
Fusion protein of human PTHLH |
|
Full name: |
parathyroid hormone-like hormone |
|
Synonyms: |
HHM, PLP, BDE2, PTHR, PTHRP |
|
SwissProt: |
P12272 |
|
ELISA Recommended dilution: |
1000-5000 |
|
IHC positive control: |
Human liver cancer and Human thyroid cancer |
|
IHC Recommend dilution: |
25-100 |

 購物車
購物車 幫助
幫助
 021-54845833/15800441009
021-54845833/15800441009